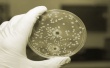
Сальмонеллы в Югре нашли в мясе птицы и куриных яйцах

Россия

|
Рынок мяса птицы: за кем будущее? 07.11.2014 |

|
Литва интересуется возможностями на сельскохозяйственном рынке Бразилии 07.11.2014 |

|
Свинский ввоз свинины в Крым запретят 07.11.2014 |

|
В магазине Вышнего Волочка обнаружены сосиски с повышенным содержанием бактерий 07.11.2014 |

|
Мясо птицы возвращено отправителю 07.11.2014 |

|
29 октября в Новосибирске проходили конгрессы "Молочная промышленность Сибири" и "Мясная промышленность Сибири" 07.11.2014 |

|
Неприхотливый жирохвостик приносит прибыль 07.11.2014 |

|
ОЗПП: Одной только маркировкой мяса делу не поможешь 07.11.2014 |

|
В России выпуск мяса и субпродуктов убойных животных в сентябре увеличился до 162 тыс. тонн 07.11.2014 |
|
Сальмонеллы в Югре нашли в мясе птицы и куриных яйцах 07.11.2014 |


